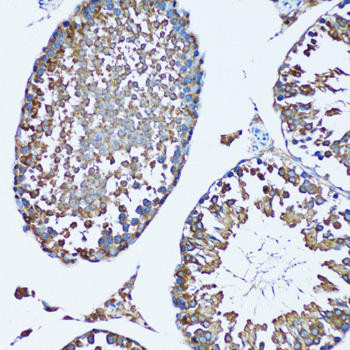
SQS/FDFT1 Rabbit Polyclonal Antibody (CAB6229)

Description
| Product Name: | Human FDFT1 Recombinant Protein |
| Product Code: | RPPB1636 |
| Size: | 10µg |
| Species: | Human |
| Target: | FDFT1 |
| Synonyms: | Farnesyl-Diphosphate Farnesyltransferase 1, SqualeneSynthase, SQS, SS, FPP:FPP Farnesyltransferase, EC 2.5.1.21, DGPT, ERG9, Presqualene-Di-DiphosphateSynthase, Squalene Synthetase, Farnesyl-Diphosphate, Farnesyltransferase, FDFT1. |
| Source: | Escherichia Coli |
| Physical Appearance: | Sterile Filtered colorless solution. |
| Formulation: | FDFT1 protein solution (0.25 mg/ml) containing 20mMTris-HCl buffer (pH 8.0), 10% glycerol and 0.4M Urea. |
| Stability: | Store at 4°C if entire vial will be used within 2-4 weeks. Store, frozen at -20°C for longer periods of time. For long term storage it is recommended to add a carrier protein (0.1% HSA or BSA).Avoid multiple freeze-thaw cycles. |
| Purity: | Greater than 85.0% as determined by SDS-PAGE. |
| Amino Acid Sequence: | MGSSHHHHHH SSGLVPRGSH MGSMEFVKCL GHPEEFYNLV RFRIGGKRKV MPKMDQDSLS SSLKTCYKYLNQTSRSFAAV IQALDGEMRN AVCIFYLVLR ALDTLEDDMT ISVEKKVPLL HNFHSFLYQP DWRFMESKEKDRQVLEDFPT ISLEFRNLAE KYQTVIADIC RRMGIGMAEFLDKHVTSEQE WDKYCHYVAGLVGIGLSRLF SASEFEDPLV GEDTERANSM GLFLQKTNII RDYLEDQQGG REFWPQEVWS RYVKKLGDFA KPENIDLAVQCLNELITNAL HHIPDVITYL SRLRNQ |
Farnesyl-Diphosphate Farnesyltransferase 1, also known as FDFT1 is amembrane-associated enzyme sited at a branch point in the mevalonate pathway. FDFT1belongs to the phytoene/squalene synthase family. FDFT1 is the 1st specificenzyme in cholesterol biosynthesis, which catalyzes the dimerization of 2molecules of farnesyl diphosphate in a two-step reaction to form squalene.
FDFT1 Human Recombinant produced in E.Coli is a single,non-glycosylated polypeptide chain containing 306 amino acids (1-283 a.a) andhaving a molecular mass of 35.4 kDa.�FDFT1 is fused to a 23 amino acid His-tag at N-terminus& purified by proprietary chromatographic techniques.
| UniProt Protein Function: | FDFT1: a membrane-associated enzyme located at a branch point in the mevalonate pathway. The encoded protein is the first specific enzyme in cholesterol biosynthesis, catalyzing the dimerization of two molecules of farnesyl diphosphate in a two-step reaction to form squalene. [provided by RefSeq, Jul 2008] |
| UniProt Protein Details: | Protein type:Oxidoreductase; EC 2.5.1.21; Endoplasmic reticulum; Lipid Metabolism - steroid biosynthesis; Membrane protein, integral; Transferase; Membrane protein, multi-pass Chromosomal Location of Human Ortholog: 8p23.1-p22 Cellular Component: endoplasmic reticulum; endoplasmic reticulum membrane Molecular Function:farnesyl-diphosphate farnesyltransferase activity Biological Process: cholesterol biosynthetic process; steroid biosynthetic process |
| NCBI Summary: | This gene encodes a membrane-associated enzyme located at a branch point in the mevalonate pathway. The encoded protein is the first specific enzyme in cholesterol biosynthesis, catalyzing the dimerization of two molecules of farnesyl diphosphate in a two-step reaction to form squalene. [provided by RefSeq, Jul 2008] |
| UniProt Code: | P37268 |
| NCBI GenInfo Identifier: | 585126 |
| NCBI Gene ID: | 2222 |
| NCBI Accession: | P37268.1 |
| UniProt Secondary Accession: | P37268,Q96GT0, B3KQ95, B4DJE5, B4DT56, B7Z1J3, |
| UniProt Related Accession: | P37268 |
| Molecular Weight: | 43,060 Da |
| NCBI Full Name: | Squalene synthase |
| NCBI Synonym Full Names: | farnesyl-diphosphate farnesyltransferase 1 |
| NCBI Official Symbol: | FDFT1�� |
| NCBI Official Synonym Symbols: | SS; SQS; DGPT; ERG9�� |
| NCBI Protein Information: | squalene synthase |
| UniProt Protein Name: | Squalene synthase |
| UniProt Synonym Protein Names: | FPP:FPP farnesyltransferase; Farnesyl-diphosphate farnesyltransferase |
| UniProt Gene Name: | FDFT1�� |
| UniProt Entry Name: | FDFT_HUMAN |